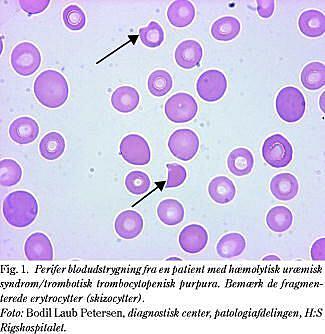

1. En 16-årig dreng blev indlagt akut med feber, konfusion, oligurisk nyreinsufficiens, anæmi, trombocytopeni og purpura.
a. Hvad fejler patienten?
b. Hvilke differentialdiagnostiske overvejelser bør man gøre sig?
c. Hvordan stilles diagnosen?
d. Hvordan skal patienten behandles?
2. Hvilke udsagn vedrørende NSAID og akut nyreinsufficiens er sande?
a. NSAID kan give anledning til akut interstitiel lymfocytær nephritis og oftest reversibel nyreinsufficiens, der evt. kan være ledsaget af nefrotisk syndrom.
b. NSAID giver hyppigt anledning til papilnekrose.
c. NSAID kan give anledning til en hastigt forløbende ekstrakapillær glomerulonephritis.
d. NSAID kan give anledning til en hæmodynamisk betinget akut nyreinsufficiens, der er betinget af, at den prostaglandinmedierede dilatation af den afferente arteriole ophæves, hvilket kan medføre reversibel nyreiskæmi og nedsat glomerulær filtrationstryk.
e. Risikoen for NSAID-medieret akut nyreinsufficiens øges ved bl.a. bestående nyresygdom, behandling med ACE-hæmmere, hjerte- og leverinsufficiens samt salt- og volumendepletion af enhver genese.
f. Selektive COX 2-hæmmere kan altid anvendes uden risiko for akut nyrepåvirkning.
3. Hvilke af følgende tilstande kan være primær årsag til nefrotisk syndrom?
a. Diabetisk nefropati.
b. Membranøs glomerulonephritis.
c. Amyloidose.
d. Systemisk lupus erythematosus.
e. Cirrhosis hepatis.
f. Kronisk interstitiel nefropati.
4. Voksne patienter med nefrotisk syndrom:
a. har oftest hyperkolesterolæmi og dyslipidæmi.
b. har øget tromboserisiko.
c. bør altid tilbydes steroidbehandling.
d. har øget infektionsrisiko.
e. bør altid have foretaget nyrebiopsi.
f. bør som hovedregel behandles med en ACE-hæmmer uanset blodtryksniveauet, hvis ikke det nefrotiske syndrom kan bringes i remission.
5. Følgende bivirkninger ved ACE-hæmmerbehandling er veldokumenterede:
a. Impotens.
b. Hyperkaliæmi.
c. Angioneurotisk ødem der er en potentielt livstruende komplikation, der kan optræde måneder til år efter behandlingsstarten.
d. Hyponatriæmi.
e. Hoste.
f. Øget risiko for fosterskader hvis ACE-hæmmere gives under graviditet.
6. Nefropati ved myelomatose kan manifestere sig som:
a. Nyreinsufficiens som følge af hyperkalcæmi med kalciuri og evt. nefrokalcinose.
b. Kronisk tubulointerstitiel nefropati.
c. Fanconi-syndrom med absorptionsdefekt, der fører til excessivt tab af aminosyrer, glukose, fosfat og bikarbonat pga. toksisk virkning af udfiltrerede lette kæder på proksimale tubulusceller.
d. Sekundær amyloidose.
e. Myelomnyre med et karakteristisk histologisk billede med cylindre af afstødte tubulusceller og evt. mangekernede kæmpeceller i distale tubuli og samlerør.
f. Benign nefrosklerose.
Svar